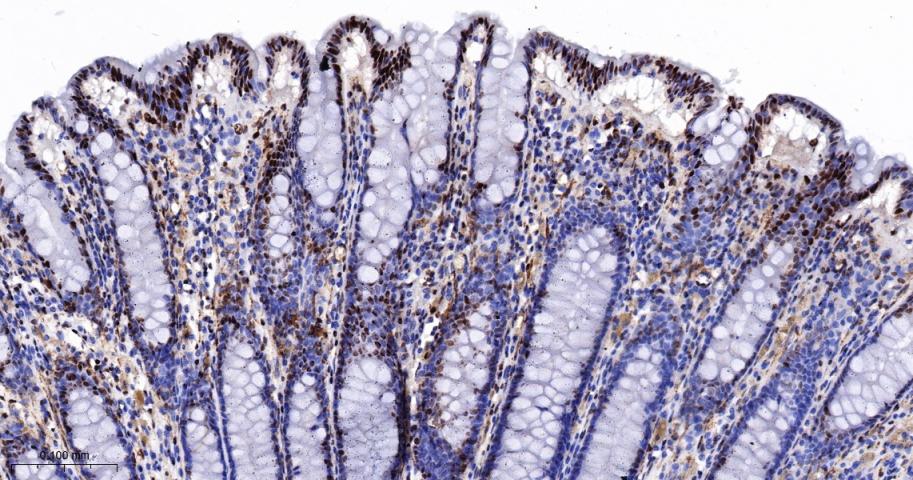
Ku80 Recombinant Rabbit mAb(bs

相关产品推荐更多 >

Anti-4-1BB & TPBG/5t4 Reference Antibody (Apv-527 Biosimilar)(BIO1017SM)-100ug/1mg/5mg
¥4320
Mouse IgA Rabbit pAb, HRP conjugated(bs-0774R-HRP)-100ul
¥2980
LXR beta Rabbit pAb(bs-18450R)-50ul/100ul/200ul
¥1180
RNF22/TRIM3 Rabbit pAb(bs-9174R)-50ul/100ul/200ul
¥1180
NGFB Rabbit pAb, PE-Cy5 conjugated(bs-0067R-PE-Cy5)-100ul
¥2980
万千商家帮你免费找货
0 人在求购买到急需产品
- 详细信息
- 文献和实验
- 技术资料
- 应用范围:
产品信息以Bioss网站为准
- 规格:
50ul/100ul
| 规格: | 50ul | 产品价格: | ¥1400.0 |
|---|---|---|---|
| 规格: | 100ul | 产品价格: | ¥2500.0 |
| 产品编号 | bsm-52512R |
| 英文名称 | Ku80 Recombinant Rabbit mAb |
| 中文名称 | DNA修复酶Ku-80重组兔单抗 |
| 英文别名 | 86 kDa subunit of Ku antigen; ATP dependent DNA helicase 2 subunit 2; ATP dependent DNA helicase II 80 kDa subunit; ATP dependent DNA helicase II 86 Kd subunit; ATP dependent DNA helicase II; ATP-dependent DNA helicase 2 subunit 2; ATP-dependent DNA helicase II 80 kDa subunit; CTC box binding factor 85 kDa; CTC box-binding factor 85 kDa subunit; CTC85; CTCBF; DNA repair protein XRCC5; KARP 1; KARP1; Ku 80; Ku autoantigen 80kDa; Ku86; Ku86 autoantigen related protein 1; KUB 2; KUB2; Lupus Ku autoantigen protein p86; NFIV; Nuclear factor IV; Thyroid lupus autoantigen; Thyroid-lupus autoantigen; TLAA; X ray repair complementing defective repair in Chinese hamster cells 5(double strand break rejoining); X-ray repair complementing defective repair in Chinese hamster cells 5(double-strand-break rejoining); X-ray repair cross-complementing protein 5; Xray repair complementing defective repair in Chinese hamster cells 5; XRCC 5; XRCC5; XRCC5_HUMAN. |
| 产品应用 | WB=1:500-2000, IHC-P=1:100-500, IHC-F=1:100-500, ICC/IF=1:50-200, IF=1:100-500 Not yet tested in other applications. |
| 交叉反应 | Human |
| 抗体来源 | Rabbit |
| 免疫原 | A synthesized peptide derived from human Ku80 |
| 亚型 | IgG |
| 性状 | Liquid |
| 纯化方法 | affinity purified by Protein A |
| 克隆类型 | Recombinant |
| 理论分子量 | 83 kDa |
| 浓度 | 1mg/ml |
| 储存液 | 0.01M TBS (pH7.4) with 1% BSA, 0.02% Proclin300 and 50% Glycerol. |
| 研究领域 | Epigenetics and Nuclear Signaling > DNA / RNA > DNA Damage & Repair > Non Homol. End Joining |
| 亚基 | Heterodimer of a 70 kDa and a 80 kDa subunit. |
| 亚细胞定位 | Nucleus. Chromosome. |
| 相似性 | Belongs to the ku80 family. Contains 1 Ku domain. |
| 功能 | Single stranded DNA-dependent ATP-dependent helicase. Has a role in chromosome translocation. The DNA helicase II complex binds preferentially to fork-like ends of double-stranded DNA in a cell cycle-dependent manner. It works in the 3'-5' direction. Binding to DNA may be mediated by XRCC6. Involved in DNA non-homologous end joining (NHEJ) required for double-strand break repair and V(D)J recombination. The XRCC5/6 dimer acts as regulatory subunit of the DNA-dependent protein kinase complex DNA-PK by increasing the affinity of the catalytic subunit PRKDC to DNA by 100-fold. The XRCC5/6 dimer is probably involved in stabilizing broken DNA ends and bringing them together. The assembly of the DNA-PK complex to DNA ends is required for the NHEJ ligation step. In association with NAA15, the XRCC5/6 dimer binds to the osteocalcin promoter and activates osteocalcin expression. The XRCC5/6 dimer probably also acts as a 5'-deoxyribose-5-phosphate lyase (5'-dRP lyase), by catalyzing the beta-elimination of the 5' deoxyribose-5-phosphate at an abasic site near double-strand breaks. XRCC5 probably acts as the catalytic subunit of 5'-dRP activity, and allows to 'clean' the termini of abasic sites, a class of nucleotide damage commonly associated with strand breaks, before such broken ends can be joined. The XRCC5/6 dimer together with APEX1 acts as a negative regulator of transcription. |
| 保存条件 | Shipped at 4℃. Store at -20℃ for one year. Avoid repeated freeze/thaw cycles. |
| 注意事项 | This product as supplied is intended for research use only, not for use in human, therapeutic or diagnostic applications. |
| 背景资料 | The protein encoded by this gene is the 80-kilodalton subunit of the Ku heterodimer protein which is also known as ATP-dependant DNA helicase II or DNA repair protein XRCC5. Ku is the DNA-binding component of the DNA-dependent protein kinase, and it functions together with the DNA ligase IV-XRCC4 complex in the repair of DNA double-strand break by non-homologous end joining and the completion of V(D)J recombination events. This gene functionally complements Chinese hamster xrs-6, a mutant defective in DNA double-strand break repair and in ability to undergo V(D)J recombination. A rare microsatellite polymorphism in this gene is associated with cancer in patients of varying radiosensitivity. |
| 应用 | 推荐稀释比例 |
| {WB} | {1:500-2000} |
| {IHC-P} | {1:100-500} |
| {IHC-F} | {1:100-500} |
| {ICC/IF} | {1:50-200} |
| {IF} | {1:100-500} |

25 ug total protein per lane of various lysates (see on figure) probed with Ku80 monoclonal antibody, unconjugated (bsm-52512R) at 1:1000 dilution and 4°C overnight incubation. Followed by conjugated secondary antibody incubation at r.t. for 60 min.

4% Paraformaldehyde-fixed Hela (H) cell; Triton X-100 at r.t. for 20 min; Antibody incubation with (Ku80) monoclonal Antibody, unconjugated (bsm-52512R) 1:100, 90 min at 37°C; followed by conjugated Goat Anti-Rabbit IgG antibody (green, bs-40295G-FITC) at 37°C for 90 min, DAPI (blue, C02-04002) was used to stain the cell nuclei. PBS instead of the primary antibody was used as the blank control.

Paraformaldehyde-fixed, paraffin embedded Human Lung Cancer; Antigen retrieval by boiling in sodium citrate buffer (pH6.0) for 15 min; The section was incubated with Ku80 Monoclonal Antibody, Unconjugated (bsm-52512R) at 1:200 overnight at 4°C, followed by conjugation to the bs-0295G-HRP and DAB (C-0010) staining.

Paraformaldehyde-fixed, paraffin embedded Human melanoma; Antigen retrieval by boiling in sodium citrate buffer (pH6.0) for 15 min; The section was incubated with Ku80 Monoclonal Antibody, Unconjugated (bsm-52512R) at 1:200 overnight at 4°C, followed by conjugation to the bs-0295G-HRP and DAB (C-0010) staining.

Paraformaldehyde-fixed, paraffin embedded Human glioblastoma; Antigen retrieval by boiling in sodium citrate buffer (pH6.0) for 15 min; The section was incubated with Ku80 Monoclonal Antibody, Unconjugated (bsm-52512R) at 1:200 overnight at 4°C, followed by conjugation to the bs-0295G-HRP and DAB (C-0010) staining.

Paraformaldehyde-fixed, paraffin embedded Human Colon Cancer; Antigen retrieval by boiling in sodium citrate buffer (pH6.0) for 15 min; The section was incubated with Ku80 Monoclonal Antibody, Unconjugated (bsm-52512R) at 1:200 overnight at 4°C, followed by conjugation to the bs-0295G-HRP and DAB (C-0010) staining.
Paraformaldehyde-fixed, paraffin embedded Human Colon; Antigen retrieval by boiling in sodium citrate buffer (pH6.0) for 15 min; The section was incubated with Ku80 Monoclonal Antibody, Unconjugated (bsm-52512R) at 1:200 overnight at 4°C, followed by conjugation to the bs-0295G-HRP and DAB (C-0010) staining.

Paraformaldehyde-fixed, paraffin embedded Human Stomach; Antigen retrieval by boiling in sodium citrate buffer (pH6.0) for 15 min; The section was incubated with Ku80 Monoclonal Antibody, Unconjugated (bsm-52512R) at 1:200 overnight at 4°C, followed by conjugation to the bs-0295G-HRP and DAB (C-0010) staining.

Paraformaldehyde-fixed, paraffin embedded Human Breast Cancer; Antigen retrieval by boiling in sodium citrate buffer (pH6.0) for 15 min; The section was incubated with Ku80 Monoclonal Antibody, Unconjugated (bsm-52512R) at 1:200 overnight at 4°C, followed by conjugation to the bs-0295G-HRP and DAB (C-0010) staining.
风险提示:丁香通仅作为第三方平台,为商家信息发布提供平台空间。用户咨询产品时请注意保护个人信息及财产安全,合理判断,谨慎选购商品,商家和用户对交易行为负责。对于医疗器械类产品,请先查证核实企业经营资质和医疗器械产品注册证情况。
文献和实验该产品被引用文献
[IF={{ preprint }}] {Dawn T Bravo. et al.Durable reconstitution of sinonasal epithelium by transplant of CFTR gene corrected airway stem cells.biorxiv.2025 Jan 26:2025.01.24.634776.} {} {}
技术资料暂无技术资料 索取技术资料
文献支持
Ku80 Recombinant Rabbit mAb(bsm-52512R)-50ul/100ul
¥1400 - 2500





